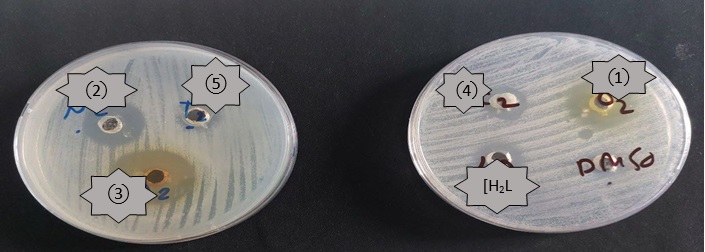

Document Type : Original Article
Authors
Department of Chemistry, College of Education for Pure Sciences, Ibn-Al-Haitham, University of Baghdad, Baghdad, Iraq
Abstract
[4-Chloro-5-(N-(5,5-dimethyl-3-oxocyclohex-1-en-1-yl) sulfamoyl)-2-((furan-2-ylmethyl) amino) benzoic acid] is the ligand[H2L1]. [H2L1] was synthesized and identified using Fourier transform infrared (FT-IR), 1H, 13C-NMR, CHN, mass spectra, and UV-Vis spectroscopy methods. To detect mixed ligand complexes, analytical and spectroscopic approaches such as micro-analysis, conductance, UV-visible, magnetic susceptibility, and FT-IR spectra were utilized. Its mixed ligand complexes [M(L1) (Q)Cl2] and complexes [Pd(L1) (Q)] and [Pt(L1) (Q)Cl2]; [H2L1] = β-enaminone ligand =L1 and Q= 8-Hydroxyquinoline = L2]. The results showed that the complexes were synthesized utilizing the molar ratio M: L1:L2 (1:1:1). For the metal complexes Co(II), Ni(II), Cd(II), and Pt(IIII), a six-coordinate octahedral geometry was proposed, whereas the Pd(II) complex was square planar. By Using the agar well diffusion method, the ligands and complexes were evaluated for antibacterial activity against Staphylococcus aureus and Escherichia coli. The studies demonstrate that the ligand and its complexes have variable activity against the bacterial types. Some of the complexes had an effect on affected bacteria, while others had less inhibitory action than the ligand. Also, the produced ligand and its metal complexes have been tested for fungi (Candida albicans); the complexes exhibited suppressing activity against fungi compared to the ligand prepared from them.
Graphical Abstract
Keywords
Main Subjects
Introduction
Enaminones have received great attention in organic synthesis due to their importance as precursors for developing several bioactive heterocyclic compounds. Due to the presence of both electrophilic and nucleophilic sites in its structure, enaminone derivatives have a wide range of applications as intermediates [1]; therefore, they have also been made used as starting materials for the synthesis of anti-inflammatory, antibacterial, anticonvulsant, and antitumor agents [2], as well as in the production of naturally occurring alkaloids. The significant advantages of enaminone derivatives are their stability under simulated physiological pH conditions and low levels of toxicity [3]. The conjugated system of β-enaminone function is a functional group in the drug industry. Enaminones produced from β-carbonyl molecules are relatively stable, most likely owing to keto-enol and imine-enamine tautomeric equilibrium (Scheme 1) [4]. Notably, molecule’s structure shows a strong intramolecular hydrogen bond along the heterodienic O=C–C=C–NH moiety, which takes the shape of a six-membered ring and makes the structure stiffer [5].

Scheme 1: Tautomeric equilibria of β-enaminones
5,5-dimethylcyclohexane-1,3-dione is an organic compound that belongs to the cyclic ß-diketones type [6]. These white to light yellow crystallines are also known as dimedone, methone, dimethyldihydro resorcinol and cyclomethone. The melting point of C8H12O2 (M.wt = 140.179 g/mol) is 147-150 °C (420-423 K). It is stable in ambient conditions and soluble ethanol, methanol, and water, as well as inorganic solvents [6-8]. It is one of the most prominent cyclic 1,3-dicarbonyls, and its uses may be found in a variety of various fields, including industrial, synthetic organic chemistry, and analytical chemistry [9].
Furosemide chemical name is 4-chloro-2-[(2-furanylmethyl)-amino]-5-sulfamoylbenzoic acid [10, 11]. It is known by the generic names Furosemide and Lasix [12]. It is a loop diuretic with a high ceiling that is used to treat edema and hypertension associated with congestive heart failure, renal disease, and cirrhosis of the liver liver cirrhosis [13, 14]. Its molecule includes potential hydrogen bond donor and acceptor groups: -SO2NH2, NH, and COOH [15].
The mixed ligand may play an essential part in the biological sector, as seen by the numerous different ways that enzymes are known to be activated by metal ions [16]. N- and O- donor ligands were utilized in the production of metal complexes to study a variety of antifungal and antimicrobial activities [17]. Organic bi-dentate ligands have been the most important class of ligands in coordination chemistry, and they have numerous applications in various fields. The ligands are composed of donor atoms, such as nitrogen, oxygen, and carbonyl groups. Consequently, its own interaction with metal ions results in the formation of complexes with different geometries that are biologically active. In latest years, mixed ligand transition metal complexes have gained prominence. These complexes have been studied for their utility in various fields. Some metal-ligand complexes catalyzed oxidation, oxidative cleavage, reduction, etc. [18, 19]. It is well established that mixed ligand chelates play an important essential role in biological processes such as the activation of activating enzymes, storage and transport of and storing and transporting substances across membranes [20].
8-Hydroxyquinoline is a white to off-white crystal or powder that is insoluble in water but freely soluble in aqueous mineral acids, acetone, ethanol, and chloroform [21]. The chemical compound 8-Hydroxyquinoline (8-HQ, 8-quinolinol, C9H7NO, oxine) [22] is a small, bicyclic compound widely used in medicinal chemistry, analytical chemistry, nuclear medicine, and as an imaging agent in nuclear medicine.
Numerous applications exist for the 8-HQ molecule; In medicine, 8-HQ and its derivatives are utilized as antimicrobials, anticancer properties, and anti-neurodegeneration. Whilst While in agriculture, they are employed as fungicides and insecticides [23, 24].
Shashikanth et. al. [25] collection of reactions to produce β-enaminones was successfully done using 5,5-dimethyl-1,3-cyclohexanedione, amines, and BiOCl fakes as catalysts enhanced by visible light. The produced BiOCl fakes were characterized using a variety of various analytical techniques and examined for photo-catalytic application using methylene blue dye under a variety of various experimental conditions. The uses of 5,5-dimethyl-1,3-cyclohexanedione to synthesize β-enaminones and their derivatives in the presence of visible light irradiation. The method utilized to prepare the photocatalyst is easily scaled up for bulk as it consumes a maximum of 10 min. Additionally, it reduces costs because no sophisticated equipment is required, Scheme 2.

Scheme 2: Synthesis β-enaminone by using BiOCl fakes as the catalyst
Hassan J. Kadhom et al. [26] created β-enaminones and their complexes. Approximately 63% of the ligands were synthesized from amines (pyrimidine-2,4-diamine) and 1,3-dicarbonyl compounds (dimedone). Its mixed ligand complexes (ML13ph) [M = Co(II), Ni(II), Cu(II), Zn(II), and Cd(II); (H1L1) = β-enaminone ligand=L1 and (3ph) = 3-aminophenol=L2]. Results indicate that complexes are formed with a molar ratio of M: L1:L2 (1:1:1). To form a suitable complex, a tetradentate β-enaminone ligand with N3O donor atoms is coordinated to Co(II), Ni(II), Cu(II), Zn(II), and Cd(II) ions. The antifungal and antibacterial properties of the synthesized ligand and its mixed ligand complexes have been evaluated against various pathogenic fungi and bacteria. Compared to the standard antibiotic ciprofloxacin, the biological activity of these compounds was superior.
In this study, attempts were made to synthesize Co(II), Ni(II), Pd(II), Cd(II), and Pt(IIII) mixed ligand complexes of ligand [H2L1] and 8-Hydroxyquinoline. All complexes were characterized utilizing spectroscopic techniques, and their biological activity was studied.
Materials and Methods
Every chemical was analytical grade and had not been further purified before usage.
Analytical and physical measurements
Shimadzu (FT-IR)-8300 Infrared Spectrophotometer was used to record FT-IR spectra in the (4000–400) cm–1 range. Spectra were recorded on potassium bromide (KBr) discs and Csl discs in the 400-200 cm-1 registered on Shimadzu 8400s FT-IR. The Electro-thermal Stuart (SMP40) was utilized for melting point measurement. Electronic spectra were recorded from (200-1100 nm) for 10-3 M solutions in DMSO at room temperature using a Shimadzu 1800 (UV-Vis) spectrophotometer with a quartz cell of 1.00 cm in length. Microanalysis (CHN) analyzer on a Heraeus instrument (Vario EL) was used to measure elemental microanalyses. The amount of chloride present in complexes was measured using a potentiometric titration technique using a (686-Titro Processor-665. Dosimat Metrohm Swiss). Magnetic moments (μeff BM) were determined utilizing a magnetic susceptibility balance (Sherwood-Scientific). The 1H-NMR spectra of the ligands were determined in DMSO-d6 as a solvent, Utilizing tetramethyl silane (TMS) as an internal standard on Agilent technologies-500 MHz spectrometer. Chemical shifts are measured in ppm downfield from the TMS reference. Electrospray mass spectroscopy was utilized to determine the ligands in the positive mode on the Agilent Sciex ESI-MS. The metal ratios of the complexes were determined with the help of the atomic absorption (AA) technique. This was done with an atomic absorption spectrophotometer made by Shimadzu (model AA 680 GBC 933 plus).
Synthesis of the ligand [H2L1]
A 5,5-dimethyl cyclohexane-1,3-dione (0.105 g, 0.749 moles) was dissolved in absolute benzene 10 mL with a few drops of glacial acetic acid with constant, furosemide (0.25 g, 0.75 mmole) dissolved in 25 mL absolute benzene with a few drops of DMSO were added with continual stirring. The solutions were mixed in a round bottom flask 100 mL, the mixture was then stirred continuously until it converted into a light-yellow solution. The resulting solution was refluxed for 7 hours until the light-yellow precipitate was noted, TLC was used to monitor the reaction. At room temperature, the reaction mixture was allowed to cool. The light-yellow precipitate had a weight of 0.27 g, Yield = % 79.4, m.p = 162 °C, Scheme 3.
Synthesis of mixed ligand metal complexes
The metal solution of CoCl2.6H2O (0.078 g, 0.33 mmole) in 5 mL of ethanol was stirred for 10 minutes. The ligand solution [H2L1] (0.15 g, 0.33 mmole) in 15 mL of ethanol after being adjusted to pH = 8 utilizing a few drops of potassium hydroxide solution was added to the metal solution. In addition, 8-Hydroxyquinoline (0.0479 g, 0.33 mmole) in 5 mL of ethanol was added to the metal solution described above. The resultant mixture was heated for 4 hours under reflux conditions. A solid complex was formed; It was collected by filtration and dried for 24 hours at ambient temperature. An olive solid was obtained. Weight (0.19 g), Yield = (70.3 %), m.p = >270 °C. The method utilized to prepare the complexes of Ni(II), Cd(II), Pd(II), and Pt(IIII) ions was a similar approach to that described in the section on the preparation of the Co(II) complex (Scheme 4). The micro-analysis of results and a few physical characteristics for ligand(H2L1) and the prepared complexes are in Table 1.

Scheme 3: Synthetic route for the ligand [H2L1]

Scheme 4: The suggested chemical structure of the complexes
Table 1: Elemental analysis information and some physical properties for ligand (H2L1) and the prepared complexes

Results and Discussion
FT ـIR Spectral data for ligand [H2L1], 8-HQ and K2[Co(L1)(Q)Cl2] (1), K2[Ni(L1)(Q)Cl2] (2), [Pd(L1)(Q)] (3), K2[Cd(L1)(Q)Cl2] (4) and [Pt(L1)(Q)Cl2] (5) complexes
As shown in Figure S1 (Supporting information), the N-H stretching vibration is responsible for the sharp band at 3375 cm-1, and the N-H enaminone is responsible for the band at 3251 cm-1 and υ OH is responsible for the stretching band at 3498 cm-1. It was determined that the υ C-H aromatic stretching vibrations were responsible for the band at 3082 cm-1. The stretching band υ C-H aliphatic is responsible for the bands detected at 2958 cm-1 and 2873 cm-1. The bands at 1681 cm-1 and 1616 cm-1 were attributed to C=O ketone and C=O stretching vibrations respectively. The stretching bands υ asymmetric S=O and υ symmetric S=O are responsible for the bands detected at 1346 cm-1 and 1165 cm-1 [27]. The stretching band υ C=N is responsible for the band detected at 1616 cm-1 [28]. As well as the stretching band at 1562 cm-1 allotted to υ C=C. Finally, the stretching band at 1242 cm-1 was attributed to υ C-N stretching vibration [29]. Also, the spectrum for 8-Hydroxyquinoline show a band at 3479 cm-1 is attributable to υ O-H stretching vibration. The bands at 3182 and 3047 cm-1 were allotted to υ C-H aromatic stretching vibration. In addition, the band at 1600 cm-1 was allotted to the υ C=N stretching vibration. Finally, the υ C=C stretching vibration appears at 1577 cm-1 [30].
The attribution of the characteristic bands in the FT-IR spectrum for the ligand [H2L1] and its complexes is described in Table 2. The ligand [H2L1] contains an N-H secondary amine group at 3375 cm-1, which remained in the complexes and had frequencies at 3414, 3387, 3379, 3417, and 3379, while the band at 3251 cm-1 in the FT-IR spectrum of the ligand [H2L1] caused by the N-H enaminone stretching vibration indicates that the ligand is loose. Moreover, the band disappearance of the hydroxyl group at 3498 cm-1 in all complexes is due to the replacement of the potassium ion from potassium hydroxide in place of the hydrogen ion in the carboxyl group. As well as, the FT-IR spectra for 8-hydroxyquinoline have a band at 3479 cm-1 that is caused by the O-H group stretching vibration. However, on complexation, these bands disappear for complexes 1, 2, 3, 4 and 5, demonstrating that the coordination occurs through the oxygen atom of the hydroxyl group for (8-HQ) and the nitrogen atom of the enamine group for [H2L1].
The band at 1600 cm-1 for the C=N of 8-hydroxyquinoline, but this band has been shifted to a lower frequency at 1604, 1608, 1600, (1600), and 1600 cm-1 for complexes 1, 2, 3, 4, and 5 respectively, suggesting that the coordination is via the nitrogen atom of the C=N group. Because oxygen and nitrogen atoms are coordinated to the metal atom, the carbonyl group and the imine group have lower frequencies.
In FT-IR complexes, the appearance of new bands at 547, 586, 543, 582, 540, 563, 532, 586, and 540, 563 cm-1 were allotted to υ M-O for complexes 1, 2, 3, 4 and 5 indicating that to the oxygen of ligands are included in coordination with metals ions. In addition, υ M-N was assigned to the appearance of new bands at 412, 447, 459, 459, 432, 459, 432, 459, and 432, 459 cm-1 for 1, 2, 3, 4, and 5 complexes [31-33].
At lower frequencies of the complexes, the appearance of new bands at 368, 351, 372, 351, 381, 351 and 378, 349 cm-1 were allotted to υ M-Cl for 1, 2, 4, and complexes [33]. The FT-IR spectra for complex Cd(II) as shown in Figure S2 (Supporting information).
Table 2: FTـ IR spectral data (wave number) cm-1 of [H2L1], (8-HQ), K2 [Co(L1)(Q)Cl2] (1) ,K2[Ni(L1)(Q)Cl2] (2), [Pd(L1)(Q)] (3), K2[Cd(L1)(Q)Cl2] (4) and [Pt(L1)(Q)Cl2] (5)

Nuclear magnetic resonance spectra of the ligand [H2L1]
1H-NMR spectrum of the ligand [H2L1]
Figure S3 (Supporting information) represents the 1H-NMR spectrum of [H2L1]. The spectrum shows the singlet signal at δ = 13.16 ppm is assigned to the O-H proton of the carboxylic acid group [34]. The singlet signal at δ = 8.6 ppm is attributed to the one proton for the N-H enamine group of S-NH, and the singlet signal at δ = 8.41 ppm is allotted to the proton for the N-H of C8-NH secondary amine. The aromatic signals in the [H2L1] spectra are single chemical shifts at δ=8.36ppm, δ=7.11ppm and are assigned to protons of C4 and C7 aromatic ring [35, 36]. Table 3 provides a summary of all of these references.
13C-NMR spectrum for the precursor [H2L1]
The 13C-NMR spectrum of [H2L1]. In the middle of the DMSO-d6 solvent, as depicted in Figure S4 (Supporting information), the first carbonyl group for an aliphatic ring was detected around δ=169.09 ppm. The carbonyl group for aromatic ring observed around δ=168.82 ppm. The chemicals shift at δ=152.83 ppm and δ = 151.79 ppm allotted to C8 for C8-NH group and C16 for C16-NH respectively [37, 38]. Multiples of chemical shifts at δ=133.78-110.99 ppm range are allotted to C6, C5, C4, C7 for the aromatic ring. The chemical shifts at δ= 143.17 ppm, δ= 136.66 ppm, δ= 108.62 ppm, and δ= 108.09 ppm were assigned to C14, C11, C12, and C13, respectively, for the furan ring. The chemical shift at δ= 102.90 ppm to C3 for C3-CO and C17 for C17-CO. The chemical shifts at δ= 40.88 ppm were attributed to C10, C19, and C21 for the CH2 groups. The chemical shift to DMSO solvent occurs at δ= 39.97 ppm. The chemical shift at δ= 32.58 ppm refers to C20 for the aliphatic ring. Finally, the carbon atoms C22 of CH3 groups resonated with the chemical shifts at δ = 28.41 ppm [39, 40]. Table 4 gives a summary of the results.
Table 3: 1H-NMR spectrum data for the precursor [H2L1]

Table 4: 13C-NMR spectrum data for precursor [H2L1]

Mass spectrum of the precursor [H2L1]
Positive ESI-MS for [H2L1] is seen in Figure S5 (Supporting information),). No peak was visible on the spectrum at m/z = 452, which may be attributable to the parent compound's molecular ion [M-H]+. While the peak appeared at 450, which could be attributed to [M-2]+ [41]. As well as the appearance of the peak at m /z = 407, which can be traced to [C19H20ClN2O5S]+. Resulting from the fragment of the carboxyl group included in the ligand. The fragmentation pattern of [H2L1] is shown in Table 5.
UV-Vis spectra of ligand [H2L1],8-HQ, and their metal complexes
Table 6 gives the UV-Vis spectra of [H2L1], 8-HQ, and their complexes K2 [Co(L1) (Q)Cl2] (1), K2 [Ni(L1) (Q)Cl2] (2), [Pd(L1) (Q)] (3), K2 [Cd(L1) (Q)Cl2] (4) and [Pt(L1) (Q)Cl2] (5) complexes that measured in DMSO, in the range 200-1000 nm. Figures S6 and S7 (Supporting information),) Electronic spectrum of K2 [Cd(L1) (Q)Cl2] and [Pt(L1) (Q)Cl2] complexes.
Table 5: A Fragmentation pattern belonging to[H2L1]

Table 6: UV-Vis spectral data of [H2L1], 8-HQ and mixed ligand complexes in DMSO solution

Biological activity for the ligand [H2L1],8-Hydroxyquinoline and their complexes K2[Co(L1)(Q)Cl2] (1), K2[Ni(L1)(Q)Cl2] (2), [Pd(L1)(Q)] (3), K2[Cd(L1)(Q)Cl2 ] (4), [Pt(L1)(Q)Cl2 ] (5)
The biological activity of the ligand [H2L1] and a number of its metal complexes 1, 2, 3, 4, and 5, were tested for their antibacterial activity against Staphylococcus aureus which is a Gram-positive bacterium, and Escherichia coli, which is a Gram-negative bacterium, as well as the fungi (Candida albicans).
The following conclusions are drawn from the information recorded and displayed in the Table 7.
Using the concentration (10-2M):
Escherichia coli: The ligand [H2L1] and the complex 3 displayed similar activity in inhibiting Escherichia coli compared to the rest of the complexes. At varying rates, the complexes inhibited testing bacteria, with 3 >2 >1>4 = 5 being the sequence of decreasing activity.
Staphylococcus aureus: The complex 2 showed higher activity in inhibiting Staphylococcus aurous than the rest of the same ligand complexes and the ligand [H2L1]. The Complexes inhibited testing bacteria at varied rates, with 2 > 3 = 4 > 5 > 1 the order of decreasing activity being. Complex 1 showed similar inhibition to the ligand [H2L1].
Candida albicans: The complex 3 offered a higher activity in inhibiting Candida albicans than the rest of the same ligand complexes and the ligand [H2L1]. The complexes inhibited testing the fungi at varied rates, with 3 > 1 > 2 > 5 > 4 the order of decreasing activity. For information, Complex 4 showed less inhibitory activity than the ligand [H2L1]. Figures 1, 2 and 3 show the biological activity of [H2L1] and its complexes on Escherichia Coli, Staphylococcus aureus and Candida albicans at concentration of 10-2M.
Utilizing the concentration (10-3M)
Escherichia coli: The ligand [H2L1] revealed higher activity in inhibiting Escherichia coli than their complexes. The Complexes inhibited tested bacteria at varying rates, with 1 = 5 >3 = 4 >2 being the sequence of decreasing activity. Complexes 2 and 3 and 4 showed less inhibitory activity than the ligand [H2L1].
Staphylococcus aureus: The complex 1 displayed higher activity in inhibiting of Staphylococcus aureus than the rest of the same ligand complexes and the ligand [H2L1]. At varying rates, the Complexes inhibited testing bacteria, with 1 > 2= 3 = 4 > 5 the order of decreasing activity.
Candida albicans: The ligand [H2L1] and the complex 1, 3, and 4 displayed similar activity inhibiting Candida albicans. The Complexes inhibited testing the fungi at varied rates, with 1 = 3 = 4 > 2 > 5 the order of decreasing activity.
Some complexes are inhibiting because of the increased lipophilicity of the complexes. Overton and Chelation’s theory could explain this increased activity of metal complexes. The positive charge of the metal in the chelated complex is partially probably shared with the ligand donor atoms, resulting in electron delocalization throughout the entire chelate ring. This, enhances the lipophilicity of the metal chelate and facilitates its passage via the lipoid layers of bacterial membranes [42]. Figures 4, 5 and 6 show the biological activity of [H2L1] and its complexes on Escherichia Coli, Staphylococcus aureus and Candida albicans at concentration of (10-3M).
Figures 7 and 8 illustrate Evolution of [H2L1] and its complexes against Escherichia Coli, Staphylococcus aureus and Candida albicans growth at concentrations 10-2M and 10-3 M.
Table 7: Inhibition zone diameter in (mm) for the ligand [H2L1]and their complexes

Figure 1: The biological activity (Staphylococcus auras) of the mixed-ligand complexes K2 [Co(L1)(Q)Cl2] (1), K2[Ni(L1)(Q)Cl2)] (2), [Pd(L1)(Q)] (3), K2[Cd(L1)(Q)Cl2)] (4) ,[Pt(L1)(Q)Cl2] (5) at concentration 10-2M

Figure 2: The biological activity (Escherichia coli) of the mixed-ligand complexes K2 [Co(L1)(Q)Cl2] (1), K2[Ni(L1)(Q)Cl2)] (2),[Pd(L1)(Q)] (3), K2[Cd(L1)(Q)Cl2)] (4), [Pt(L1)(Q)Cl2] (5) at concentration 10-2M
Figure 3: The biological activity (candida albicans) of the mixed-ligand complexes K2 [Co(L1)(Q)Cl2] (1), K2[Ni(L1)(Q)Cl2)] (2),[Pd(L1)(Q)] (3), K2[Cd(L1)(Q)Cl2)] (4), [Pt(L1)(Q)Cl2] (5) at concentration 10-2 M

Figure 4: The biological activity (Staphylococcus auras) of the mixed-ligand complexes K2 [Co(L1)(Q)Cl2] (1), K2[Ni(L1)(Q)Cl2)] (2),[Pd(L1)(Q)] (3), K2[Cd(L1)(Q)Cl2)] (4), [Pt(L1)(Q)Cl2] (5) at concentration 10-3M

Figure 5: The biological activity (Escherichia coli) of the mixed-ligand complexes where K2 [Co(L1)(Q)Cl2] (1), K2[Ni(L1)(Q)Cl2)] (2),[Pd(L1)(Q)] (3), K2[Cd(L1)(Q)Cl2)] (4), [Pt(L1)(Q)Cl2] (5) at concentration 10-3M

Figure 6: The biological activity (candida albicans) of the mixed-ligand complexes K2 [Co(L1)(Q)Cl2] (1), K2[Ni(L1)(Q)Cl2)] (2),[Pd(L1)(Q)] (3), K2[Cd(L1)(Q)Cl2)] (4), [Pt(L1)(Q)Cl2] (5) at concentration 10-3M

Figure 7: Evolution of [H2L1] and its complexes against Candida albicans, E. coli and S. aureus growth at concentration 10-2M

Figure 8: Evolution of [H2L1] and its complexes against Candida albicans, E. coli and S. aureus growth at concentration 10-3M
Conclusion
1-The β-enaminone acted in the form of bidentate ligand through a nitrogen atom in imine (N-H) and oxygen atom in (C=O) keto. with the central metal ions M(II): Co, Ni, Pd, Cd also Pt (IIII) with complexes of its general molecular formula: [M (L1) (Q) Cl2] and complexes [Pd (L1) (Q)] and [Pt(L1) (Q)Cl2]. 2-For all prepared complexes Co(II), Ni(II), Cd(II), Pt(IIII), the octahedral geometrical structure was recommended while Pd(II) the Square planar geometrical.
Acknowledgments
Thanks, and appreciation to the presidency of the University of Baghdad and to the Deanship of the College of Education for Pure Sciences Ibn Al-Haitham and everyone who contributed to this research.
Funding
This research did not receive any specific grant from funding agencies in the public, commercial, or not-for-profit sectors.
Authors' contributions
All authors contributed to data analysis, drafting, and revising of the paper and agreed to be responsible for all the aspects of this work.
Conflict of Interest
There are no conflicts of interest in this study.
HOW TO CITE THIS ARTICLE
Maysam B. Abdulsalam, Ahmed T. Numan. Synthesis, Characterization, and Biological Activity of Mixed ligand Complexes from 8-Hydroxyquinoline and New ligand for β-Enaminone. Chem. Methodol., 2022, 6(12) 962-976


